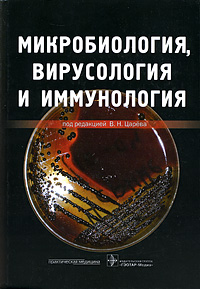

Словарь представляет собой систематизированное справочное издание, содержащее около 600 гистологических терминов, применяемых в учебной литературе по цитологии, эмбриологии и общей гистологии. К каждому термину дается соответствие на латыни и английском ...
|

Изложены современные методы лабораторной диагностики бактериальных инфекций, а также заболеваний, вызываемых вирусами, грибами, простейшими и гельминтами, распространенных в нашей стране и за рубежом. Приведены методы антимикробных воздействий и ...
|

Дан обзор по строению растительной клетки в сравнении с животной, показаны основные характеристики мембранных и немембранных органоидов клетки, детально рассмотрено строение ядерного аппарата клетки, хромосом и их различных типов. Уделено внимание ...
|

Во втором томе изложены основные принципы микробиологической диагностики и частная микробиология, в которой описаны свойства возбудителей бактериальных, вирусных, грибковых и протозойных инфекций. Помимо свойств возбудителей излагаются особенности ...
|

Учебное издание содержит современную информацию по патогенным и условнопатогенным микроорганизмам, их идентификации, а также заболеваниям, которые они вызывают. Состоит из разделов по общей и частной микробиологии и итогового тестового экзамена. Общая ...
|

В учебном пособии изложены главнейшие научные открытия в биохимической и молекулярной генетике, приведшие к современным представлениям о сущности генетической информации и веществе наследственности, а также о некоторых механизмах регуляции работы генома в ...
|
|
|

Книгу отличает большое количество прекрасных иллюстраций. Она дает краткое и вместе с тем достаточно полное представление о каждой группе протистов. Общая часть включает историю протозоологии и характеристику клетки протистов. В третьей части учебника ...
|
|
|
|

Рассмотрены цитологические и молекулярные основы наследственности, анализ наследования признаков при внутривидовой и межвидовой гибридизации и на популяционном уровне, геномные и хромосомные мутации, явление ЦМС, инбредное вырождение и гетерозис. ...
|

Пособие посвящено одной из основных проблем современной биологии - происхождению и эволюции полового размножения и его основной функции - поддержания генетического разнообразия. Рассмотрены молекулярно-генетические механизмы детерминации и дифференцировки ...
|

Настоящая книга - вторая в серии словарей "Биологические науки". Словарь содержит более 1000 статей, объясняющих часто употребляемые термины современной микробиологии. Для студентов и преподавателей естественных факультетов вузов, ссузов, специалистов и ...
|

Приводятся основные сведения о клетках позвоночных животных и человека, о внутриклеточных структурах, даются основные представления о биохимических и функциональных свойствах клеточных органелл, а также об их характерных патологических изменениях. Описаны ...
|

В этой книге представлены методические разработки по курсу "Общая генетика", соответствующие учебному плану биолого-почвенного факультета Санкт-Петербургского государственного университета (СПбГУ) в том виде, как он осуществлялся в 2006/07 учебном году. В ...
|
|

В справочнике представлены наиболее распространенные референтные величины лабораторных и функциональных показателей, полученные при обследовании практически здоровой части населения европейского региона России. Впервые приводятся данные по различным ...
|

Все главы переработаны и дополнены в связи с развитием медицинской науки и практики. Существенно дополнены главы по многофакторным заболеваниям, профилактике, лечению наследственных болезней, экологической генетике и фармакогенетике. Весь теоретический ...
|
В книге рассмотрены биохимически важные соединения, их строение и свойства, основные процессы с их участием в тканях ротовой полости человека. Большое внимание уделено регуляции и интеграции отдельных метаболических процессов, объясняются механизмы ...
|
|
|
|